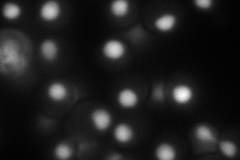
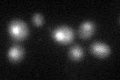

View description
snRNP protein component of spliceosomal snRNPs, required for pre-mRNA splicing and snRNP biogenesis; in null mutant newly-synthesized snRNAs are destabilized and 3'-end processing is slowed
Localization:
Intensity:
Fold change:
Significance:
-
C’ GFP library in SD

nucleus22.78 -
N' NOP1pr-GFP in SD

nucleus50.6009 -
N' TEF2pr-mCherry in SD
nucleus104.644 -
N' NATIVEpr-GFP in SD

below threshold27.7427 -
N' TEF2pr-VC and Cyto-VN in SD

#N/A0 -
C’ GFP library in SD+DTT
nucleus22.961No -
C’ GFP library in SD+H2O2

nucleus24.731.08No -
C’ GFP library in Starvation Media

nucleus22.120.97No -
C’ GFP library on the background of Pup2-DaMP

nucleus -
C’ GFP library on the background of CCT mutant

nucleus22.23570.975623No
